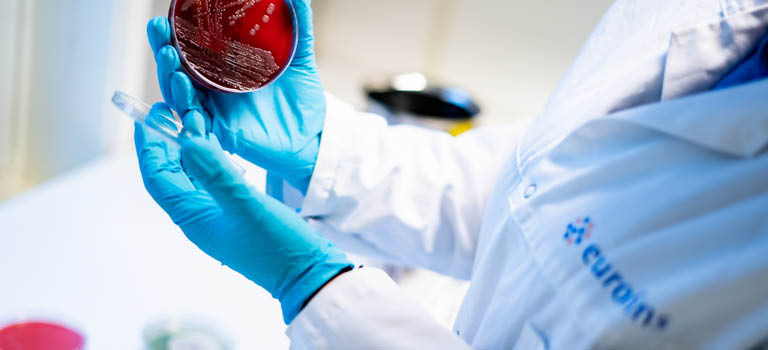
Analysetjenester

Food & Feed Testing
Søke
Søke >>
Mattrygghet fra hav og jord til bord
Hurtigtilgang
Enkle løsninger for bestilling, resultater, transport og utstyr.
Siste nytt
- Fagdag: Fett og oljer 20-04-2026
- FSSC 22000 ver 7 09-03-2026
- Webinar Food Integrity 15-02-2026
- Deltagere Mattrygghetsskolen 11-02-2026
- Neonikotinoider 05-02-2026